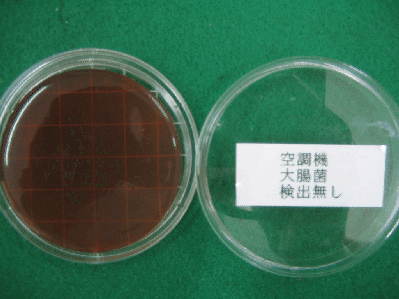

ŽÊ^î•ñ ˆê——
yŽÊ^ƒ^ƒCƒgƒ‹zF‹ó’²ƒ_ƒNƒg´‘|ƒTƒ“ƒvƒ‹
¡ƒCƒ“ƒfƒbƒNƒX
y| P.4|z
‘Oƒy[ƒW
ŽŸƒy[ƒW
| ˆÊ’uNo | ƒtƒ@ƒCƒ‹–¼ |
ˆÊ’uNo | ƒtƒ@ƒCƒ‹–¼ |
ˆÊ’uNo | ƒtƒ@ƒCƒ‹–¼ |
ˆÊ’uNo | ƒtƒ@ƒCƒ‹–¼ |
ˆÊ’uNo | ƒtƒ@ƒCƒ‹–¼ |
| 31 | 00061905.bmp |
32 | 00062025.bmp |
33 | 00062031.bmp |
34 | 00062030.bmp |
35 | 00062029.bmp |
 |
 |
 |
 |
|
| ׋ۑª’è |
׋ۑª’è |
׋ۑª’è |
׋ۑª’è |
׋ۑª’è |
HŽí |
| ƒAƒ}ƒmƒ‹ƒ~ƒl°ƒ^°×‹Û |
ƒAƒ}ƒmƒ‹ƒ~ƒl°ƒ^°×‹Û |
”÷¶•¨•ªÍ(”|—{ŒŸ¸) |
”÷¶•¨•ªÍ(”|—{ŒŸ¸) |
”÷¶•¨•ªÍ(”|—{ŒŸ¸) |
Ží•Ê |
| ׋ۑª’è’† |
„‘E´ò“xŒÂ”20,000 |
ˆê”Ê׋ۂ̔ÉB(36Žž |
ˆê”Ê׋ۂ̔ÉB(36Žž |
ˆê”Ê׋ۂ̔ÉB(36Žž |
×•Ê |
| |
|
|
|
|
‘ª“_ |
ˆÊ’uNo | ƒtƒ@ƒCƒ‹–¼ |
ˆÊ’uNo | ƒtƒ@ƒCƒ‹–¼ |
ˆÊ’uNo | ƒtƒ@ƒCƒ‹–¼ |
| 36 | 00062023.bmp |
37 | 00062024.bmp |
38 | 00062022.bmp |
 |
 |
 |
| Woƒt¨ƒ‹ƒ^°ó‹µ |
Woƒt¨ƒ‹ƒ^°ó‹µ |
Woƒt¨ƒ‹ƒ^°ó‹µ |
|
|
HŽí |
| •²o‰ñŽû‘O |
•²o‰ñŽûŒã |
|
|
|
Ží•Ê |
| |
|
|
|
|
×•Ê |
| |
|
|
|
|
‘ª“_ |